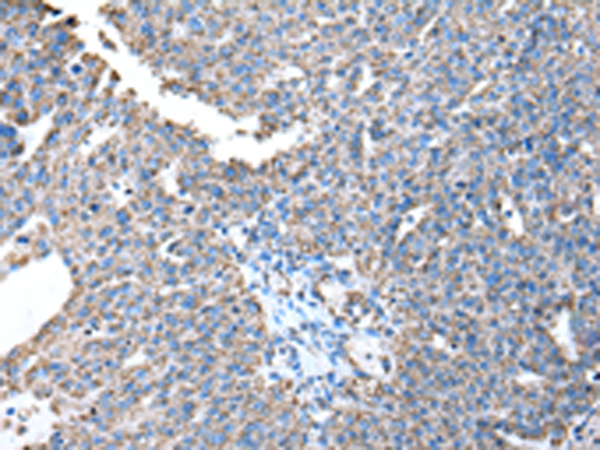

中文名稱(chēng):兔抗ATP5A1多克隆抗體
|
Background: |
This gene encodes a subunit of mitochondrial ATP synthase. Mitochondrial ATP synthase catalyzes ATP synthesis, using an electrochemical gradient of protons across the inner membrane during oxidative phosphorylation. ATP synthase is composed of two linked multi-subunit complexes: the soluble catalytic core, F1, and the membrane-spanning component, Fo, comprising the proton channel. |
|
Applications: |
WB, IHC |
|
Name of antibody: |
ATP5A1 |
|
Immunogen: |
Fusion protein of human ATP5A1 |
|
Full name: |
ATP synthase, H+ transporting, mitochondrial F1 complex, alpha subunit 1, cardiac muscle |
|
Synonyms: |
OMR; ORM; ATPM; MOM2; ATP5A; hATP1; MC5DN4; ATP5AL2; COXPD22; HEL-S-123m |
|
SwissProt: |
P25705 |
|
IHC positive control: |
Human breast cancer and Human esophagus cancer |
|
IHC Recommend dilution: |
25-100 |
|
WB Predicted band size: |
60 kDa |
|
WB Positive control: |
Jurkat, 293T and MCF7 cell |
|
WB Recommended dilution: |
500-2000 |

購(gòu)物車(chē)
幫助
021-54845833/15800441009
